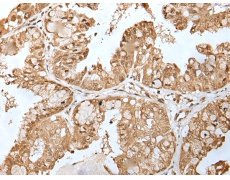
一抗

中文名稱:兔抗ZNF202多克隆抗體
技術(shù)規(guī)格
Background:
Transcriptional repressor that binds to elements found predominantly in genes that participate in lipid metabolism. Among its targets are structural components of lipoprotein particles (apolipoproteins AIV, CIII, and E), enzymes involved in lipid processing (lipoprotein lipase, lecithin cholesteryl ester transferase), transporters involved in lipid homeostasis (ABCA1, ABCG1), and several genes involved in processes related to energy metabolism and vascular disease.
Applications:
ELISA, IHC
Name of antibody:
ZNF202
Immunogen:
Fusion protein of human ZNF202
Full name:
zinc finger protein 202
Synonyms:
ZSCAN42; ZKSCAN10
SwissProt:
O95125
ELISA Recommended dilution:
5000-10000
IHC positive control:
Human esophagus cancer and human liver cancer
IHC Recommend dilution:
25-100


 購物車
購物車 幫助
幫助
 021-54845833/15800441009
021-54845833/15800441009